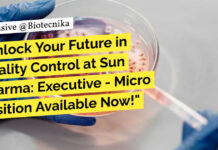
Quality Control at Sun Pharma: Executive - Micro Position Available Now!
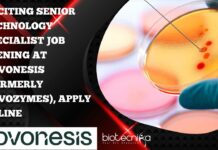
Novonesis Food Technology Industry

Home 2024
Yearly Archives: 2024
Enveda Senior Scientist Invitro Pharmacology! Biological Sciences Apply Online
Enveda Senior Scientist Invitro Pharmacology! Biological Sciences Apply Online
Senior Scientist - Invitro Pharmacology
Hyderabad: India Pipeline – Biology / Full-Time / On-Site
Proud to be recognized...
Biocon Biologics Executive Job For Life Sciences – Apply Online
Biocon Biologics Executive Job For Life Sciences - Apply Online
Senior Executive - Biosimilars Downstream Manufacturing
Bengaluru, Karnataka, India
About the job
Responsibilities
Scheduling, planning, executing, monitoring, and...
Quality Control Executive/Senior Executive at Biocon Biologics – Apply Now!
Biocon Biologics QC Job Opening - Apply Online Now
QC Physicochemical - Executive/Senior Executive
Greater Bengaluru Area
About the job
About the Company:
Biocon Biologics Limited, a subsidiary of...
Quality Control at Sun Pharma: Executive – Micro Position Available Now!
Quality Control at Sun Pharma: Executive - Micro Position Available Now!
Title: Executive - Micro
Date: Jul 18, 2024
Location: Mohali - Quality Control
Company: Sun Pharmaceutical Industries...
Central University of Tamil Nadu SRF Recruitment – Applications Invited
Central University of Tamil Nadu SRF Recruitment - Applications Invited
CENTRAL UNIVERSITY OF TAMIL NADU
THIRUVARUR- 610 005, TAMIL NADU
Department of Epidemiology and Public Health
Advertisement for...
Central Food Technological Research Institute Hiring MSc Biotech & Microbiology – Apply Online
CFTRI Biotechnology Project Associate Recruitment - Apply Online
CFTRI Biotechnology Project Associate Recruitment - Apply Online. Interested and eligible applicants can check out all of...
Biotecnika Times Newsletter 17.07.2024 – ICMR JRF 2024 Registration Extended, CSIR NET June 2024...
Applications & Registrations EXTENDED For ICMR JRF 2024 | DHR-ICMR 2024 - Biomedical Research Eligibility Test (BRET)
Check details and apply for the ICMR JRF...
THSTI Life Science Vacancy Notification: Rs. 42k Pay For SRF Role, Apply Now
THSTI Life Science Vacancy Notification: Rs. 42k Pay For SRF Role, Apply Now
Rolling Recruitment Notice No. : THS/RN/01/2024/07-I
VACANCY NOTIFICATION
Project: Development of highly infectious BSL4...
Bioinformatics Research Fellow Position at Institute of Life Sciences, Bhubaneswar, Attend Walk-In
Bioinformatics Research Fellow Position at Institute of Life Sciences, Bhubaneswar, Attend Walk-In
INSTITUTE OF LIFE SCIENCES
(An Autonomous Institute under the Dept. of Biotechnology, Ministry of...
Novonesis MSc, BTech & MTech Biotech, Biochem Associate Job – Apply Online
Novonesis Associate Job Opening - MSc, BTech & MTech Apply Online
Associate Industry Technology Specialist
Locations: Bangalore
Time type: Full time
Posted on: Posted Yesterday
Job Requisition ID: JR102419
Are...
Exciting Senior Technology Specialist Job Opening at Novonesis (Formerly Novozymes), Apply Online
Novonesis Food Technology Industry Technology Specialist, Apply Online
Senior Industry Technology Specialist
Locations: Bangalore
Time type: Full time
Posted on: Posted Yesterday
Job Requisition ID: JR102363
Are you ready for...
Syngene Biotech, Biochem, Structural Biology & Biophysics Associate Scientist Job, Apply Online
Syngene Associate Scientist Job, Apply Online
Associate Scientist
Bengaluru, Karnataka, India
About the job
Location: Bangalore
About Syngene:
Syngene (www.syngeneintl.com) is an innovation-led contract research, development and manufacturing organization offering...
Dr. Reddy’s Laboratories Ltd Clinical Research Associate Job For Life Sciences, Apply Online
Dr. Reddy’s Labs CRA Job For Life Sciences, Apply Online
Dr. Reddy’s Labs CRA Job For Life Sciences, Apply Online. Interested and eligible applicants can...
Exciting Clinical Trial Associate Job at Dr. Reddy’s Laboratories – Apply Now!
Clinical Trial Associate Job at Dr. Reddy’s Laboratories - Apply Now!
Clinical Trial Associate
Hyderabad, Hyderabad, India
Full-time
Job Family: Clinical Development
Sub Job Family: Clinical Operation
Business unit: Biologics
Years...
CSIR NET June 2024 Final Exam Dates Announced + City Intimation
CSIR NET June 2024 Exam Dates - CSIR NET Life Sciences Exam Dates
PUBLIC NOTICE
16.07.2024
ADVANCE INTIMATION OF EXAMINATION CITY ALLOTTED TO THE APPLICANTS
AS PER REVISED...